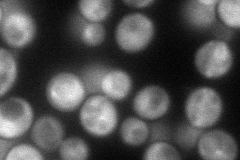
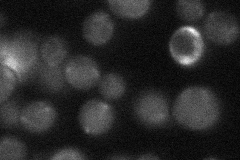

View description
Protein with CoA transferase activity, particularly for CoASH transfer from succinyl-CoA to acetate; has minor acetyl-CoA-hydrolase activity; phosphorylated; required for acetate utilization and for diploid pseudohyphal growth
Localization:
Intensity:
Fold change:
Significance:
-
C’ GFP library in SD

mitochondria145.11 -
N' NOP1pr-GFP in SD
cytosol,punctate84.3347 -
N' TEF2pr-mCherry in SD

missing0 -
N' NATIVEpr-GFP in SD
below threshold26.8577 -
N' TEF2pr-VC and Cyto-VN in SD

#N/A0 -
C’ GFP library in SD+DTT

mitochondria189.841.3No -
C’ GFP library in SD+H2O2

mitochondria120.820.83No -
C’ GFP library in Starvation Media

mitochondria128.250.88No -
C’ GFP library on the background of Pup2-DaMP

mitochondria -
C’ GFP library on the background of CCT mutant

mitochondria158.5871.09281No
